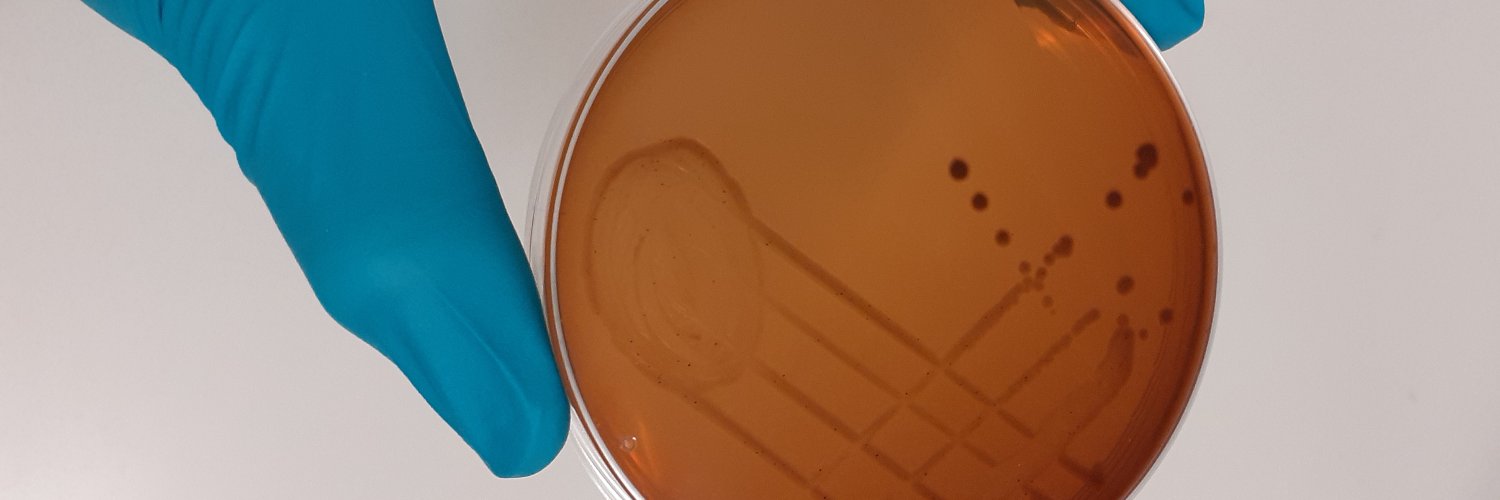
Andrew P Desbois banner

Aquaculture UK moves to Glasgow (SEC) for the first time (16-17 June). You can register for free here: aquacultureuk.com
English
Andrew P Desbois
920 posts

@DesDoesScience
Aquaculture microbiology | fish pathogens | antimicrobial resistance Snr Lecturer, Institute of Aquaculture (University of Stirling)






















